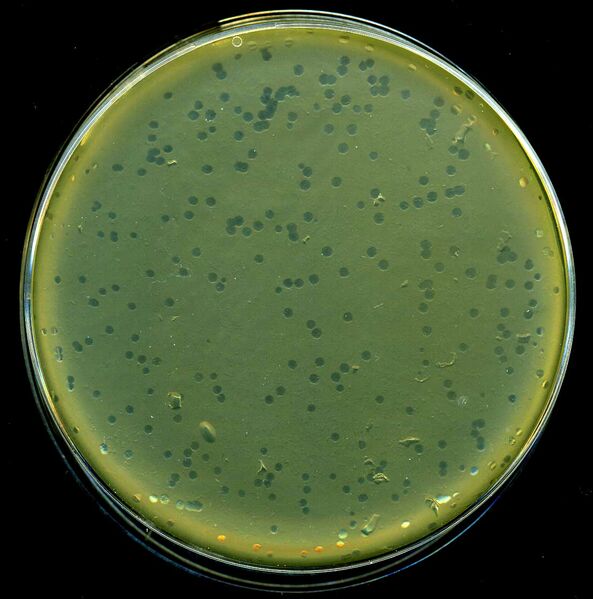
ملف:LambdaPlaques.jpg
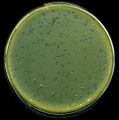
تصغير للنسخة بتاريخ 04:10، 9 أكتوبر 2023

ملف:LambdaPlaques.jpg
حجم هذه المعاينة: 593 × 599 بكسل. البعد الآخر: 1٬106 × 1٬118 بكسل.
الملف الأصلي (1٬106 × 1٬118 بكسل حجم الملف: 87 كيلوبايت، نوع MIME: image/jpeg)
وصف قصير
| Description | Plaques of Lambda Phages on E. coli XL1-Blue MRF' |
| Date | قالب:Original upload date |
| Source | No machine-readable source provided. Own work assumed (based on copyright claims). |
| Author | No machine-readable author provided. Madboy assumed (based on copyright claims). |
ترخيص
|
تاريخ الملف
اضغط على زمن/تاريخ لرؤية الملف كما بدا في هذا الزمن.
| زمن/تاريخ | صورة مصغرة | الأبعاد | مستخدم | تعليق | |
|---|---|---|---|---|---|
| حالي | ★ مراجعة معتمدة 04:10، 9 أكتوبر 2023 | | 1٬106 × 1٬118 (87 كيلوبايت) | Pastakhov (نقاش | مساهمات) | Upload https://upload.wikimedia.org/wikipedia/commons/d/dd/LambdaPlaques.jpg |
لا يمكنك استبدال هذا الملف.
وصلات
لا يوجد صفحات تصل لهذه الصورة.
